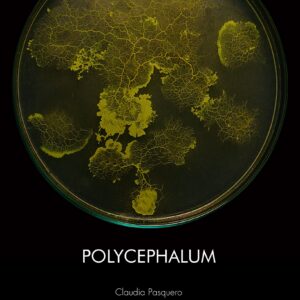

Photo: Tõnu Tunnel
Apply to the PhD programme of Architecture and Urban Planning at EKA!
You can choose between two directions: the traditional theoretical text based research and experimental design based research, which is either creative practice research or design led research by design.
The doctoral studies you can do in several domains: planning, urban design, architecture, interior architecture and landscape architecture. Doctoral studies in EKA aim to develop and reflect the creation, histories & theories as well as philosophy of these fields.
- You will create and develop new professional knowledge.
- You will learn and practice new skills, knowledge and competencies.
- You will meet and collaborate with international and creative professionals.
EKA and Royal Melbourne Institute of Technology (RMIT) have established a cooperation agreement. You can enroll in both schools and will qualify with the PhD degree from both institutions.
Info session on 8 February: doctoral studies at EKA
https://www.artun.ee/en/calendar/online-info-session-about-doctoral-studies-at-eka/
Preparation for doctoral studies:
https://www.artun.ee/en/calendar/preparation-for-doctoral-studies/
Conditions for admission to doctoral studies:
https://www.artun.ee/en/admissions/doctoral/admissions/